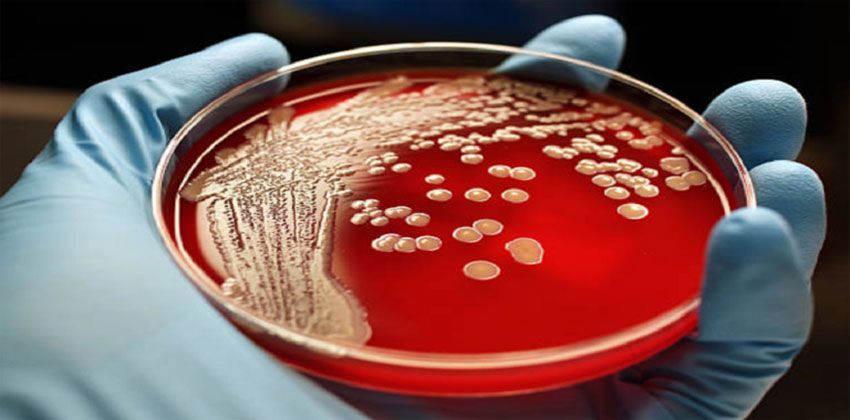
أوريغامي

“خوفو”… يبحث عن بديل لـ “كوكب الأرض”
يستعد “خوفو” لأن ينطلق، مساء اليوم الثلاثاء 17 كانون الأول، إلى الفضاء من أجل البحث
Read More

كم ساعة تحتاج للنوم وكيف يتم حسابها؟
تختلف مواعيد النوم لدى الكثيرين، كما يختلف عدد ساعات النوم، الأمر الذي يؤثر على الوظائف
Read More

ثغرة خطيرة في “واتسآب”… مستخدم واحد يمكنه تدمير حسابات كل أصدقائه
كشفت تقارير صحفية عن وجود ثغرة خطيرة في تطبيق التراسل الفوري الأشهر في العالم
Read More

لأول مرة… تطوير علاج مناعي للسرطان قريباً
يعمل باحثون أستراليون على تطوير علاج مناعي لمرض السرطان، وذلك للمرة الأولى في العالم.
Read More

دول عربية تتصدر قائمة “الأكثر هدراً للغذاء في العالم”
في الوقت الذي يواجه فيه نحو مليار شخص على مستوى العالم أزمة كبيرة في توفير
Read More
علماء يحققون اكتشافاً قد يوقف نمو “كائنات خارقة” مقاومة للعلاج
قال علماء من جامعة كامبريدج إن خيوطاً صغيرة من “أوريغامي” الحمض النووي يمكن أن تزيد فعالية
Read More

زائر فضائي يصل من خارج المجموعة الشمسية
أعلن فلكيون من التلسكوب الفضائي “هابل” التابع لوكالتي الفضاء الأميركية والأوروبية عن التقاط
Read More

فوائد اليوسفي
قالت خبيرة التغذية الألمانية إمكه ريزه إن اليوسفي يعد بمثابة مفتاح الصحة والجمال، حيث
Read More
